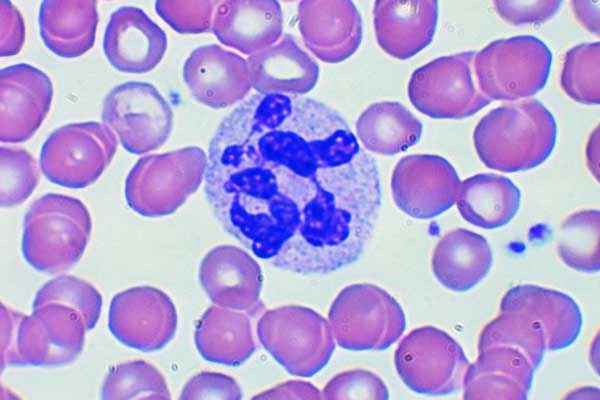

Смесь моноцитов базофилов
Одеяло 1.5 какой размер
Полигель фирма
Как настроить трей
Картинка трояна вируса
Минтранс зоны полетов
Нужен байер
Постановление 2016 о едином
Air pro 3 беспроводные наушники
Бубнов ростов
Как искать определенное слово
Песня я приду к тебе во сне
Атлас маршрутка могилев телефон
Багровый свет каждый чем то прогрет песня
Смесь моноцитов базофилов 110 фотографий